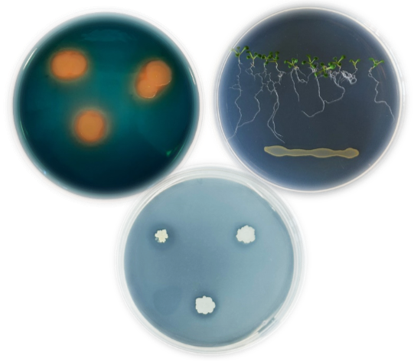

Spectatori salutem! Tisztelt Hölgyem, Uram! Kedves Kollégám!
Köszöntöm a Magyar Mikrobiológiai Társaság (MMT) honlapján. Az 1951-ben alapított MMT tagjai a mikrobiológia valamennyi jelentős ágát képviselik. Az alapítók szándékának megfelelően a Társaság célja a mikrobiológia valamennyi területének fejlesztése Magyarországon. Ennek érdekében szerteágazó tevékenységet végez. Kiemelem, hogy a Társaság minden páros évben nagygyűlést rendez (az előadások nyelve magyar). A páratlan években az International Congress of the Hungarian Society for Microbiology, ill. a Central European Forum for Microbiology nemzetközi konferenciák váltakoznak. Konferenciáinkon a résztvevők a bakteriológia, immunológia, ipari mikrobiológia, környezeti mikrobiológia és biotechnológia, mezőgazdasági és élelmiszer mikrobiológia, mikológia, parazitológia, virológia legtágabban értelmezett területén szervezett szekciókban tartanak tudományos előadásokat és mutatnak be posztereket. A konferenciák első napján egy-egy kiemelt fontosságú kérdéskört járunk körül. Társaságunk minden év április végén esedékes közgyűléséhez is előadóülés csatlakozik, amelyet a Magyar Tudományos Akadémia Mikrobiológiai Osztályközi Bizottságával együtt a mikrobiológia valamely aktuális területéről szervezünk. Meghívott nemzetközi előadóink területük kiemelten jegyzett képviselői.
A Társaság a MOTESZ (Magyar Orvostudományi Társaságok és Egyesületek Szövetsége) tagja. Ugyancsak tagja az IUMS (International Union of Microbiological Societies) és FEMS (Federation of European Microbiological Societies) nemzetközi társaságoknak. A MOTESZ a Társaság javaslatára tagokat delegál a UEMS-SMM (Union of European Medical Societies szervezetben Section for Medical Microbiology) szakmai szekcióba.
Amennyiben műveli és/vagy tanulja a mikrobiológia valamelyik ágát de még nem MMT tag, bár szeretné élvezni a tagsággal járó előnyöket, kérem vegye fel a kapcsolatot az MMT Vezetősége bármelyik tagjával, vagy keresse fel honlapunk csatlakozási felületét a Tagfelvétel gombra kattintva.
Köszöntéssel,
Kónya József
a Magyar Mikrobiológiai Társaság elnöke
TOVÁBB A MIKROBIOLÓGIA VILÁGÁBA
Extremofil baktériumok magashegységi olvadéktóban az Andokban
![]() |
A Föld élőhelyeinek egyik különleges csoportját képezik azok, ahol kizárólag extrém körülményekhez alkalmazkodott mikroorganizmusok (extremofilek) képesek életben maradni. A szélsőséges feltételek igen változatosak lehetnek, és gyakran együttesen jelentkeznek a természetben. Az extremofilek kutatása közelebb visz minket többek között a Földi élet kialakulásának és a korai mikroorganizmusok adaptációjának megértéséhez. |
Antibiózis gombafajok között
| Műemlék védelem alatt álló freskómaradványokkal borított beltéri falakról izolált penészgombák azonosításáról és egy biomolekulán alapuló védekezési lehetőségről számolunk be. | ![]() |
Kozmopolita Alternaria gombák a szőlőn
|
A szőlőt kolonizáló endofiton gombák között jelentős számban fordulnak elő az Alternaria nemzetség tagjai. Az endofiton gombák életük egy szakaszában úgy élnek a gazdanövényben, hogy nem okoznak látható tüneteket.
|
![]() |
Növekedést és terméshozamot serkentő baktérium az édesburgonyán
![]() |
A hosszútávon fenntartható mezőgazdaságban kiemelt szerep jut a mikrobiológiai alapú készítményeknek (pl. talajoltó készítmények, lombtrágyák), amelyek alapját sok esetben úgynevezett növényi növekedést serkentő baktériumok képezik. |
Vírusvadászat, avagy hogyan kutatható egy vírus, ha nincs is vírus
A vírusok utáni célzott vagy random „vadászat” sikerességét jelentősen megnövelte a szekvenálási technikák fejlődése. Lehetővé vált, hogy ismert kórképek addig ismeretlen kórokozóit azonosítsuk; hogy egy új fertőzés, járvány esetén gyorsan megtaláljuk a kórokozót, ahogy ez a SARS-CoV-2 esetében is történt. Ugyanakkor sokszor puszta „genomvadászat” zajlott/zajlik, vagyis nem klinikai tünetek miatt, hanem teljesen random mintákból új szekvenciákat keresnek és írnak le. Mindezeknek köszönhetően jelentősen megnőtt az új, korábban nem ismert vírusok száma. A felfedezéskor a vírusok nagy többségét nem izolálták, nem tudunk betegséget társítani hozzájuk, gyakorlatilag szinte semmit nem tudunk róluk. Puszta genomszekvenciaként „léteznek”, nincs vírus, amellyel a laboratóriumban dolgozhatnánk. Ez új kutatási területet nyitott meg.
Baktériumok az édesvizek diklofenák gyógyszerszennyezése ellen
A diklofenák, egy széles körben alkalmazott nem-szteroid gyulladáscsökkentő gyógyszer, amely egyre nagyobb koncentrációban mutatható ki édesvízi ökoszisztémákban. Napjaink egyik legsürgetőbb környezeti problémájává váltak ezen szennyezési források. Jelen tanulmányban a Stenotrophomonas humi DIC_5 baktériumtörzs diklofenák-lebontó képességét vizsgálták. A baktérium 75,1%-os hatékonysággal képes volt biotranszformálni a diklofenákot 1,5 mg/L kezdeti koncentráció mellett, 8 nap alatt, 3,0 g/L glükóz jelenlétében.
A SARS CoV-2 atomi erő mikroszkópos vizsgálata
| A Semmelweis Egyetem Biofizikai és Sugárbiológiai Intézet és a Nemzeti Népegészségügyi Központ Nemzeti Biztonsági Laboratórium munkatársai natív SARS-CoV-2 virionok atomi erő mikroszkópos vozsgálatával kimutatták, hogy a vírusrészecskék mechanikai és hőmérséklet hatásnak meglepően ellenállók. Cikkük a Nano Letters folyóiratban jelent meg. | ![]() |